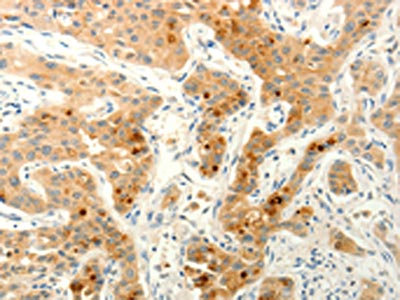

FAT4 Antibody
-
中文名稱:FAT4兔多克隆抗體
-
貨號:CSB-PA017577
-
規格:¥1100
-
圖片:
-
The image on the left is immunohistochemistry of paraffin-embedded Human liver cancer tissue using CSB-PA017577(FAT4 Antibody) at dilution 1/20, on the right is treated with synthetic peptide. (Original magnification: ×200)
-
The image on the left is immunohistochemistry of paraffin-embedded Human lung cancer tissue using CSB-PA017577(FAT4 Antibody) at dilution 1/20, on the right is treated with synthetic peptide. (Original magnification: ×200)
-
-
其他:
產品詳情
-
Uniprot No.:
-
基因名:FAT4
-
別名:Cadherin family member 14 antibody; Cadherin related family member 11 antibody; CDHF14 antibody; CDHR11 antibody; FAT atypical cadherin 4 antibody; FAT J antibody; FAT tumor suppressor homolog 4 antibody; Fat-like cadherin protein FAT-J antibody; FAT4 antibody; FAT4_HUMAN antibody; FATJ antibody; hFat4 antibody; HKLLS2 antibody; Nbla00548 antibody; Protocadherin Fat 4 antibody; Putative protein product of Nbla00548 antibody; VMLDS2 antibody
-
宿主:Rabbit
-
反應種屬:Human
-
免疫原:Synthetic peptide of Human FAT4
-
免疫原種屬:Homo sapiens (Human)
-
標記方式:Non-conjugated
-
抗體亞型:IgG
-
純化方式:Antigen affinity purification
-
濃度:It differs from different batches. Please contact us to confirm it.
-
保存緩沖液:-20°C, pH7.4 PBS, 0.05% NaN3, 40% Glycerol
-
產品提供形式:Liquid
-
應用范圍:ELISA,IHC
-
推薦稀釋比:
Application Recommended Dilution ELISA 1:2000-1:5000 IHC 1:25-1:100 -
Protocols:
-
儲存條件:Upon receipt, store at -20°C or -80°C. Avoid repeated freeze.
-
貨期:Basically, we can dispatch the products out in 1-3 working days after receiving your orders. Delivery time maybe differs from different purchasing way or location, please kindly consult your local distributors for specific delivery time.
-
用途:For Research Use Only. Not for use in diagnostic or therapeutic procedures.
相關產品
靶點詳情
-
功能:Cadherins are calcium-dependent cell adhesion proteins. FAT4 plays a role in the maintenance of planar cell polarity as well as in inhibition of YAP1-mediated neuroprogenitor cell proliferation and differentiation.
-
基因功能參考文獻:
- The results provide direct evidence that localized feedbacks on Fat4-Ds1 complexes can give rise to planar cell polarity. PMID: 28826487
- Study shows that when key regulators during mammalian cerebral cortical development are disrupted due to DCHS1-FAT4 mutations, functional cerebral asymmetries are stronger. PMID: 25930014
- Epigenetic inactivation of FAT4 contributes to gastric field cancerization. PMID: 26792292
- In hepatocellular carcinoma patients, both FAT4 expression and FAT4 mutational status significantly correlated with patient prognosis. FAT4 acts as a putative tumor suppressor that is frequently inactivated in human hepatocellular carcinoma. PMID: 26672766
- In conclusion, Fat4 expression is deceased in gastric cancer cells, leading to nuclear translocation of Yap and correlates with poor prognosis. PMID: 26575609
- FAT4 has a tumour suppressor role mediated by the modulation of Wnt/beta-catenin signalling, providing potential novel targets for the treatment of gastric cancer PMID: 26633557
- our results reveal a novel inhibitory mechanism of FAT4 gene expression through actin depolymerization during Src-induced carcinogenesis in human breast cells. PMID: 25679223
- These findings suggest that Fat and Dachsous self-bend due to the loss of Ca(2+)-binding amino acids from specific EC-EC linkers, and can therefore adapt to confined spaces. PMID: 25355906
- study defined eight additional recurrently mutated genes in SMZL; these genes are CREBBP, CBFA2T3, AMOTL1, FAT4, FBXO11, PLA2G4D, TRRAP and USH2A. PMID: 24349473
- Homozygosity mapping and whole-exome sequencing was used in the original Hennekam syndrome family with multiple affected individuals in whom no CCBE1 mutation had been detected, and identified a homozygous mutation in the FAT4 gene. PMID: 24913602
- findings show that mutations in genes encoding the receptor-ligand cadherin pair DCHS1 and FAT4 lead to a recessive syndrome in humans that includes periventricular neuronal heterotopia PMID: 24056717
- The atypical cadherin Fat4 encodes at least part of the stromal cell differentiation signal. PMID: 23974041
- the nonsynonymous variants rs1014867 (Pro4972Ser) and rs1039808 (Ala807Val) of FAT4 may contribute to esophageal cancer susceptibility PMID: 23319386
- Recurrent somatic mutations in FAT4 gene is associated with gastric adenocarcinoma. PMID: 22484628
- Fat4 may be a breast tumor suppressor gene PMID: 19048595
顯示更多
收起更多
-
相關疾病:Van Maldergem syndrome 2 (VMLDS2); Hennekam lymphangiectasia-lymphedema syndrome 2 (HKLLS2)
-
亞細胞定位:Membrane; Single-pass type I membrane protein.
-
組織特異性:Widely expressed. Expressed in fetal brain, infant brain, brain tumor and colorectal cancer.
-
數據庫鏈接:
Most popular with customers
-
-
YWHAB Recombinant Monoclonal Antibody
Applications: ELISA, WB, IHC, IF, FC
Species Reactivity: Human, Mouse, Rat
-
Phospho-YAP1 (S127) Recombinant Monoclonal Antibody
Applications: ELISA, WB, IHC
Species Reactivity: Human
-
-
-
-
-